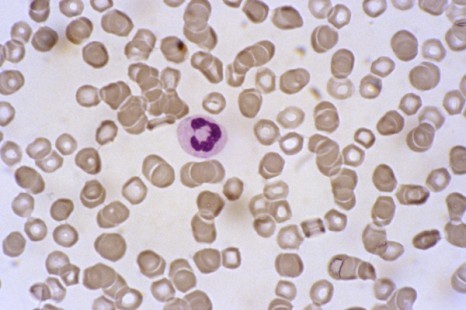

Your new post is loading...
 Your new post is loading...

|
Scooped by
CRCHDF
September 7, 2021 7:02 AM
|
Des chercheurs de l'University of Chicago Medicine ont mis à jour un nouveau mécanisme remarquable par lequel le propre système immunitaire du corps utilise certains globules blancs, les polynucléaires neutrophiles, pour éliminer les cellules cancéreuses sans endommager les cellules hôtes.
L

|
Scooped by
CRCHDF
September 6, 2021 7:18 AM
|
Cette étude japonaise confirme l'innocuité et l’efficacité d’une nouvelle thérapie par cellules souches pour supprimer la douleur chronique au genou causée par l’arthrose, une maladie qui touche environ 30% des personnes âgées de 65 à 75 ans. Plus précisément, l’étude, publiée dans la revue Stem Celles Translational Medicine (SCTM), montre que la greffe de cellules souches mésenchymateuses (CSM) autologues, dans le genou affecté, n’induit pas de tumeurs et permet, à 5 ans, chez certains patients, une réparation complète des déchirures du ménisque du genou. Bref, au fil des études, les thérapies par cellules souches se montrent très prometteuses pour réparer les articulations.

|
Scooped by
CRCHDF
September 6, 2021 6:25 AM
|
Certains patients positifs à la Covid-19 n’ont ressenti aucun symptômes pendant qu’ils étaient infectés. Néanmoins, des semaines ou mois plus tard, plusieurs études montrent que les asymptomatiques peuvent avoir d’importantes séquelles..

|
Scooped by
CRCHDF
September 6, 2021 3:56 AM
|
La pédagogie Montessori, très en vogue en France, est aussi devenue un argument de vente pour des produits parfois vendus très chers. Sauf qu'il n'existe aucune marque ou label déposé et qu'une myriade de jouets et meubles s'improvisent Montessori.

|
Scooped by
CRCHDF
September 6, 2021 3:52 AM
|
Un nouveau traitement pourrait limiter la dégénérescence discale dans les lombaires. À terme, de nombreux patients pourraient ainsi éviter de souffrir de lombalgies..

|
Scooped by
CRCHDF
September 2, 2021 9:36 AM
|
Si pour l'instant l'épidémie de Covid-19 semble contrôlée, la rentrée scolaire est tout de même surveillée de près. De trop grandes failles pourraient relancer les contaminations.
Faut-il diminuer le nombre d’élèves par classe pour favoriser la réussite scolaire? Si la question est simple, la réponse l’est beaucoup moins. Le Détecteur de rumeurs explique pourquoi.
Via DocCHI, CDI Paris

|
Scooped by
CRCHDF
September 1, 2021 4:12 AM
|
Avec des élèves de moins de 12 ans pas vaccinés et le brassage des populations, les cas de Covid-19 ont fortement augmenté dans les pays où la rentrée des classes est passée. Des médecins craignent un scénario similaire en France.

|
Scooped by
CRCHDF
September 1, 2021 4:10 AM
|
MÉDICAMENTS - Le phénomène des fausses ordonnances se développe depuis une dizaine d'années. Le 20H de TF1 a mené l'enquête.. Santé : video, Petites fraudes, grosses escroqueries… Enquête sur le fléau des fausses ordonnances.

|
Scooped by
CRCHDF
September 1, 2021 4:09 AM
|
"On est tombés le 29 août sous les 10 millions de personnes qui ne sont pas vaccinées", a déclaré le ministère de la Santé ce mardi.

|
Scooped by
CRCHDF
September 1, 2021 4:08 AM
|
La myopie se développe de manière inquiétante chez les enfants depuis le début de la pandémie. Telle est la conclusion d’une étude menée par des chercheurs hongkongais. En cause principalement, la fermeture des écoles, le confinement et l’apprentissage en ligne.

|
Scooped by
CRCHDF
September 1, 2021 4:07 AM
|
La Thaïlande connaît actuellement une vague d’infections sans précédent, avec près de 20.000 cas enregistrés par jour. Et malheureusement, à peine 8,3 % de sa population est vaccinée par u

|
Rescooped by
CRCHDF
from CREADOC Nice
September 1, 2021 4:07 AM
|
Cette publication détaille "pour l’année 2019, les capacités d’accueil et l’activité des hôpitaux et cliniques, le parcours des patients par discipline, les caractéristiques du personnel rémunéré (médical et non médical) ou encore les équipements techniques et leur répartition sur le territoire. Deux nouvelles fiches ont été ajoutées cette année, la première consacrée à l’évolution des effectifs salariés hospitaliers, la seconde aux capacités d’accueil en soins critiques (réanimation, soins intensifs et surveillance continue), données mobilisées dans la gestion de la crise sanitaire. Enfin, des éléments de cadrage permettent d’apprécier l’évolution de la santé économique et financière du secteur, et celle de son contexte juridique et réglementaire."
Via Patrice FACIN
|

|
Scooped by
CRCHDF
September 7, 2021 7:01 AM
|
Avec plus de vaccinations mais un variant Delta plus contagieux, l’Institut Pasteur s’est décidé à mettre à jour ses prédictions pour l’automne. Et cela ne devrait pas plaire aux personnes vaccinées…
Dans un monde égocentré, les différences sont trop souvent rejetées. Alors, certains courts-métrages d’animation tentent d’éveiller les consciences des
Via CREADOC Ollioules
Découvrez le rôle des établissements de santé dans la protection des données des patients et comment y parvenir.
Via Vigipharm

|
Scooped by
CRCHDF
September 6, 2021 3:55 AM
|
La consommation de fausses morilles est à l'origine d'une dizaine de cas de maladie de Charcot dans un petit village de Savoie.

|
Scooped by
CRCHDF
September 2, 2021 10:44 AM
|
Deux nouveaux variants du coronavirus sont dans le collimateur de l'OMS. Peu d'informations sont disponibles à leur sujet mais ils auraient tous les deux une résistance accrue au

|
Scooped by
CRCHDF
September 2, 2021 9:35 AM
|
L’athérosclérose est l’une des affections les plus courantes liées à l’excès de cholestérol. Elle est due à la formation de plaques d’athérome où des lipides s’accumulent sur la paroi de

|
Scooped by
CRCHDF
September 1, 2021 4:52 AM
|
Revue de sommaires juillet-août 2021, accédez aux principaux titres de la presse spécialisée : Les bienfaits du toucher, Maladie alcoolique et rechute, Violences faites aux femmes et violences intrafamiliales, la réforme de la formation aide-soignant(e),....

|
Scooped by
CRCHDF
September 1, 2021 4:10 AM
|
Davantage que la vaccination, être malade du Covid-19 accroîtrait le risque de myocardite, selon une étude américaine, publiée mardi 31 août., Le risque de myocardite, une inflammation du muscle cardiaque,

|
Scooped by
CRCHDF
September 1, 2021 4:09 AM
|
Le FFFOD, Forum des acteurs de la formation digitale, organise un webinaire de présentation de son nouveau guide : "Structure des coûts d’une formation multimodale".
Ce guide, qui sera disponible sous peu en téléchargement sur le site web du FFOD, aborde les fondamentaux d’une formation multimodale, détaille tous les postes de coûts et propose des points de repère pour aider les financeurs à évaluer les offres de formation.

|
Rescooped by
CRCHDF
from Veille sur les innovations en formation
September 1, 2021 4:09 AM
|

|
Scooped by
CRCHDF
September 1, 2021 4:08 AM
|
Des chercheurs canadiens ont mis en évidence l’existence d’une enzyme appelée CAIX indispensable à la survie des cellules cancéreuses des tumeurs solides. Son inhibition pourrait permettre d’empêcher la croissance et la propagation des tumeurs..
Nouvel Article publié par notre experte Joséphine ARRIGHI DE CASANOVA, responsable marketing et communication santé mentale chez Qare, pionnier de la téléconsultation en France. N°06, Août 2021 Selon l’OMS, environ 25 % de la population mondiale est touchée dans sa vie par un trouble mental, figurant...
Via Vigipharm
|

 Your new post is loading...
Your new post is loading...
 Your new post is loading...
Your new post is loading...